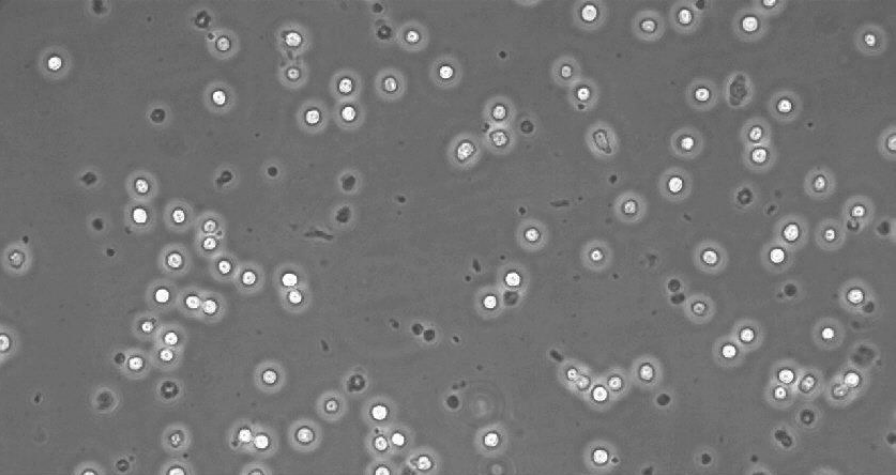
圖片3.png

date:2022-08-23 14:17:50
1. 基本信息
下面的應(yīng)用描述了小鼠巨噬細(xì)胞系RAW-264.7(生物安全等級2)在ibidi µ-Slides VI 0.4 和8孔腔室載玻片的培養(yǎng)方案。這是一個特殊的細(xì)胞系的例子,用于顯示粘附時間,細(xì)胞密度和細(xì)胞形態(tài)的示范。本應(yīng)用可根據(jù)您的具體實(shí)驗(yàn)要求進(jìn)行調(diào)整。
2. 材料
在設(shè)置中應(yīng)用下列材料:
·RAW-264.7 (murine macrophages, CLS - Cell Lines Service, Biosafety Level 2)
·Medium: RPMI 1640 with 2 mM L-Glutamin and 10% FBS
·µ-Slide VI 0.4, ibiTreat (ibidi 80606)
·µ-Slide 8 well, ibiTreat (ibidi 80826)
·Accutase (PAA Laboratories GmbH)
·1x Phosphate buffered saline (PBS)
3. 細(xì)胞培養(yǎng)與材料制備
在將細(xì)胞接種到玻片中之前,按照常規(guī)的方法培養(yǎng)細(xì)胞。
µ-Slide VI 0.4 :通道玻片和培養(yǎng)基,在37℃和5%CO2培養(yǎng)箱中培養(yǎng)過夜。這對于避免隨著時間的推移出現(xiàn)氣泡至關(guān)重要。為此,在50 ml器中填充適量的培養(yǎng)基,并輕輕地將瓶蓋擰緊。在 µ-Slide 8孔載玻片開放孔井中,氣泡可排出到大氣中。
拆開µ-Slide的包裝,把它放在µ-Slide支架上,并在準(zhǔn)備細(xì)胞懸浮液時同時將蓋子放在 Luer 適配器/孔上。
4. 播種細(xì)胞
分離細(xì)胞:
吸出培養(yǎng)瓶中的培養(yǎng)基,并用PBS洗滌細(xì)胞一次。每75cm² 燒瓶中加入3-5 ml的Accutase,并將燒瓶放入培養(yǎng)箱中以加快分離速度。如果是RAW-264.7細(xì)胞系,則大約需要8分鐘。使用Accutase分離的細(xì)胞存活率更高。

4.1. 將細(xì)胞接種到µ-Slide VI 0.4中
在µ-Slide VI 0.4建議的細(xì)胞濃度:最終細(xì)胞數(shù) 0.3 x 10 5 cells/cm²,制備濃度6 x 10 5cells/ml。通過將移液器尖端直接放在通道的入口上,將30 µl細(xì)胞懸浮液填充到每個通道中。將蓋子蓋在玻片上,在37°C和5%CO2下孵育半小時以固定細(xì)胞。
細(xì)胞貼壁后,分別用60 µl無細(xì)胞培養(yǎng)基填充儲液池。 避免將移液器吸頭直接指向通道的入口。將玻片放回培養(yǎng)箱中。
圖1:接種后一小時,在ibiTreat µ-Slide VI 0.4(貨號80606)中的RAW-264.7

圖2: 在ibiTreat µ-Slide VI 0.4中的RAW-264.7,孵育24小時后

圖3:在ibiTreat µ-Slide VI0.4中的RAW-264.7,培養(yǎng)四天后
4.2 將細(xì)胞播種在µ-Slide 8 well 中

在µ-Slide 8 well建議的細(xì)胞濃度:最終細(xì)胞數(shù) 0.3 x 10 5 cells/cm² ,制備濃度 1.1 x 10 5 cells/ml。將300 µl 的細(xì)胞懸浮液注入各孔中。將蓋子蓋在玻片上,在37°C和5% CO2中孵育。不需要進(jìn)一步添加培養(yǎng)基。

圖4:在ibiTreat µ-Slide 8 well(貨號:80826)中的RAW-264.7,播種后1小時

圖5: 在ibiTreat µ-Slide 8 well中的RAW-264.7,孵育24小時后

圖6:在ibiTreat µ-Slide 8 well中的RAW-264.7,經(jīng)過四天的培養(yǎng)
為獲得最佳的分布的勻的細(xì)胞,我們建議使用像µ-Slide VI 0.4 這樣的通道載玻片。在8孔腔室載玻片中,細(xì)胞密度可能會在孔的整個表面上因點(diǎn)而異,具體取決于細(xì)胞播種過程中的處理。
5. 免疫熒光染色
像往常一樣為您的細(xì)胞固定和染色。
注意:在 µ-Slides 中染色時注意液體的處理
µ-Slide VI 0.4 :更換液體,先吸出兩個儲液池而不排空通道。 如果您使用的是真空設(shè)備,請注意不要將吸頭直接放在通道的入口上。 用100 µl新溶液沖洗通道3次。 從一側(cè)添加新的溶液,通過通道流入另一個儲液池,然后從另一側(cè)吸出,直到兩個儲液池都排空。注意通道永遠(yuǎn)不要干涸!
µ-Slide 8孔載玻片:在 µ-Slide 8孔中,無需特殊處理措施。像在任何其他培養(yǎng)皿或孔板中一樣的交換液體。
下文中,給出了使用以下材料對細(xì)胞核和肌動蛋白絲進(jìn)行染色的示例:
細(xì)胞核:DAPI(Diamidino pheylindol dihydrochlorid) SIGMA, 32670
肌動蛋白絲:Phalloidin, Alexa Fluor ® 488 Conjugate, LONZA, PA-3010
1. 用3.7% 的PFA在PBS(pH 7.4)中室溫下固定細(xì)胞10分鐘。
2. 用PBS清洗細(xì)胞三次。
3. 用Triton X 100(0.1%)孵育細(xì)胞5分鐘。
4. 用PBS清洗細(xì)胞三次。
5. 用1%牛血清白蛋白在PBS中孵育20分鐘。
6. 用PBS清洗細(xì)胞三次。
7. 在0.2μm濃度下用鬼筆環(huán)肽Alexa For 488孵育細(xì)胞20分鐘。
8. 用PBS清洗細(xì)胞三次。
9. 用DAPI(0.5μg/ml)孵育細(xì)胞10分鐘。
10. 用PBS清洗細(xì)胞三次。
11. 完全吸出通道并用ibidi封片劑重新填充。 現(xiàn)在樣品可在顯微鏡上觀察了。保存在陰暗陰涼處可儲存數(shù)周。

圖7:在 µ-Slide VI 0.4中的RAW-264.7用DAPI(細(xì)胞核、藍(lán)色)和Phalloidin, Alexa Fluor ® 488 Conjugate(肌動蛋白絲,綠色)
ICP備案號:
滬ICP備15057650號-1
滬公網(wǎng)安備31011202005471
雷萌生物科技(上海)有限公司 保留所有版權(quán).